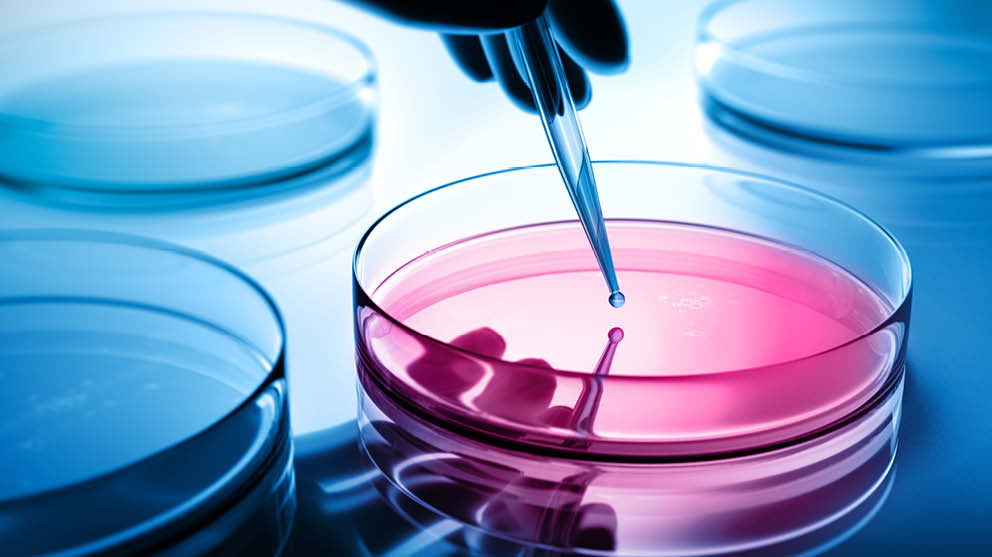

The new Product Liability Directive introduces significant changes to the EU’s product liability regime (see here for a detailed overview). Member States must implement it by December 2026. But what will its biggest challenges be? How can businesses prepare for and mitigate the new product liability risks in the EU?
Who better to ask than our International Products team, who handle such cases on a daily basis. We spoke to Katie Chandler (UK), Lena Niehoff (Germany), Vera Jurgens (Netherlands), Christopher Bakier (Austria), Librado Loriente and Íñigo Basarrate from our partner law firm ECIJA in Spain, Evelyne Friedel (France) and Seán Carroll (Ireland) about the status quo and their expectations regarding the new Product Liability Directive (new PLD).
Product liability: Where do we stand?
Which life sciences products is the Product Liability Directive currently relevant for?
Lena Niehoff (Germany): Under product liability rules, consumers can make claims relating to allegedly defective medical devices and/or medicinal products in most EU countries. Producers can be held strictly liable if consumers can prove that they have suffered an injury or damage as a result of a defective product. However, Germany has a special liability regime for medicinal products under the Federal Drug Act. National product liability legislation does not apply to medicinal products in Germany.
Does the current Product Liability Directive also apply in the UK? What are your expectations regarding the new directive following Brexit?
Katie Chandler (UK): Yes, the current PLD is implemented into the law of England & Wales by the Consumer Protection Act 1987 (CPA) under which producers are held strictly liable for any damage caused by defective products. Following Brexit, the UK will not be adopting the new PLD. That said, we have a proposed new Product Safety and Metrology Bill which will provide the UK with some flexibility to adopt or diverge from updated EU legislation and that could include the new PLD in due course with consequential amendments to the CPA.
In most EU countries, the national product liability legislation is currently closely aligned with the Product Liability Directive. Are there any special rules in your country that extend beyond the current directive?
Evelyne Friedel (France): Overall, liability for health products in France is governed by the PLD, but supplementary compensation schemes also exist (ONIAM - Office National d'Indemnisation des Accidents Médicaux).
Christopher Bakier (Austria): Basically, Austrian national legislation on product liability is aligned with the current PLD. However, provisions of the Civil Code or other laws that allow broader or different compensation for damages remain unaffected by the national transposition of the PLD.
Lena Niehoff (Germany): The situation is similar in Germany. While product liability is one of strict liability, consumers can also bring claims against producers based on tort law. However, this would require proof of fault.
Vera Jurgens (Netherlands): There are some procedural and substantive elements in Dutch law that go beyond the current PLD. The Netherlands has a well-developed class action system (Wet afwikkeling massaschade in collectieve actie, or WAMCA), which allows NGOs and representative bodies to bring collective claims, including product liability cases. Although the PLD is based on strict liability, Dutch courts may occasionally also show flexibility with the burden of proof, especially in complex product liability cases where technical evidence is difficult to obtain.
Katie Chandler (UK): Litigation funding is permitted by the English court, subject to various rules, including that funding must not breach the principles of champerty and maintenance. Funding is common in claims involving multiple claimants pursued on a group action basis in respect of personal injury/product liability claims and often against medical device manufacturers. This includes third party funding where a funder covers the costs of the proceedings in return for a share of any awarded proceeds or Damages Based Agreements which usually involves the client making payment of a percentage of damages paid by the losing side in return for legal representation. We also have a statutory compensation scheme for particular products such as vaccines which have previously been set up to resolve specific claims eg the compensation schemes dealing with HIV and Hepatitis C contamination of blood products.
Going forward: The new Product Liability Directive
What do you think will be the most impactful change by the new Product Liability Directive in your country?
Lena Niehoff (Germany): The new PLD introduces presumptions of causation and of defect, particularly for medically or technically complex cases. This brings an important change to the burden of proof. Currently, it is for the claimant to prove beyond reasonable doubt that the product is defective and has caused damage. This can be difficult to demonstrate in practice; for example, the failure of a medical device can have many different causes, which are independent of its design. Ultimately, the new presumptions of causation and of defect can be rebutted by the defendant. However, in the future, companies may have to increase their efforts to prove that they are not liable. This will require substantive evidence including sufficient documentation regarding the product documentation, amongst other things.
Evelyne Friedel (France): The evidentiary facilitations introduced will also be important in France, particularly as the new PLD allows the court, at the request of the injured party, to order the manufacturer to disclose information relating to the product.
Vera Jurgens (Netherlands): In the Netherlands, the most impactful change will likely be the explicit inclusion of software and AI-related products in the liability regime. Dutch law, like the old PLD, was not fully adapted to deal with intangible or digital elements. The new PLD’s recognition of software updates, AI models, cyber security failures as potential defects, and its broader notion of 'product' and 'damage,' will significantly expand the scope of liability, especially for tech companies, healthcare (eg digital diagnostics), and IoT sectors in the Netherlands.
ECIJA (Spain): We agree. The new PLD expands the scope of product liability by broadening both the definition of 'product' (now it expressly includes (i) software, (ii) digital manufacturing files, (iii) related digital services, and (iv) intangible or non-physical products) and 'defect' (to assess the existence of a defect, the new PLD adds new criteria to the traditional principle of 'lack of safety that a person is entitled to expect').
Christopher Bakier (Austria): One of the most impactful changes of the new PLD in Austria will be the inclusion of software (eg also AI), digital design files, and connected digital services within the scope of product liability. Under current Austrian law (PHG), liability has basically been limited to tangible, movable goods or was in certain cases strongly dependent on the individual case. Also noteworthy are the expanded criteria for product defectiveness, including cyber security risks, missing updates, and lifecycle safety obligations.
Katie Chandler (UK): I agree. As mentioned, the UK will not be adopting the new PLD. But we would at least expect the definition of 'product' in the CPA to be expanded to include software, for example. The New PLD defines 'product' as 'all movables, even if integrated into, or inter-connected with, another movable or an immovable; it includes electricity, digital manufacturing files, raw materials and software'. As such, it covers software, including apps, as well as AI systems. Further, should the presumptions of causation be implemented into the UK regime this would bring about a significant change to the existing test applied to prove causation. A claimant has the burden of proving, on the balance of probabilities, that the defendant's product caused or materially contributed to the injuries. Introducing a rebuttal presumption of causation which the defendant has to disprove shifts that burden considerably.
Seán Carroll (Ireland): Yes, one of the most significant changes in the new PLD is how its definition of 'product' has expanded to include digital elements and software. This is something that will be especially relevant within an Irish context, given the strength of Ireland's pharmaceutical and tech sectors and how it is increasingly common to see functionality such as AI and smart tracking integrated into products.
What do you think will be the biggest challenge under the new Product Liability Directive in your country?
Christopher Bakier (Austria): A potential challenge under the new PLD in Austria might be that producers may be required to disclose technical documentation or system details if courts support claimants with limited access to evidence. This raises sensitive questions around trade secrets and procedural fairness.
Vera Jurgens (Netherlands): The biggest challenge will likely be managing the disclosure obligations, and complying with the reversed burden of proof in complex systems (especially AI and multi-component products).
For Dutch businesses, this will require:
- more robust product documentation, versioning of software and firmware
- clarity on who controls which part of a complex supply chain
- possibly contractual reallocation of risk between suppliers.
Also, courts will have to grapple with technical complexity, especially regarding causation in AI-related harm — something not fully tested yet in the Dutch judiciary.
Lena Niehoff (Germany): I agree that the new disclosure obligations will be a challenge, particularly as disclosure of evidence is not common outside of common law countries. Under the new PLD, the defendant must disclose 'relevant evidence' at their disposal, limited to what is 'necessary and proportionate'. This leaves many questions open. It will be interesting to see how the new disclosure obligation is implemented into national legislation and handled by the courts. It is also important to bear in mind that the new PLD extends the limitation period for latent personal injury cases from 10 to 25 years. This is a long time to retain product documentation.
Evelyne Friedel (France): It will be essential to exercise heightened scrutiny over product compliance with national and EU legal requirements, especially in light of the presumptions of defectiveness introduced by Article 10 of the new PLD.
ECIJA (Spain): In our opinion, the key challenges for our clients under the new PLD will relate to (i) updating documentation, (ii) managing evolving products such as AI-based products, (iii) ensuring traceability in product safety and performance, and (iv) having an adequate insurance policy.
Seán Carroll (Ireland): The biggest challenge for Ireland will likely be navigating the expanded definition of 'product' to include software and AI systems. This enables manufacturers to become liable for damage caused by issues like weak cyber security or insufficient software updates even where a third party was involved in compromising the system. It should further be considered that failure to provide security updates is also a trigger for liability. Having this broadened definition is undoubtedly going to pose a challenge under the new PLD also because related services will be considered a component of the product, where it is interconnected and within the managers control.
The new PLD foresees extensive disclosure obligations, is this something that your country already has for product liability claims?
ECIJA (Spain): No, the disclosure obligations set out in Article 9 of the new PLD are not expressly provided in the current Spanish national legislation on product liability.
Christopher Bakier/Evelyne Friedel: The same is true for Austria and France.
Lena Niehoff (Germany): Germany currently does not have such disclosure obligations in its national product liability legislation either. However, under Section 84a of the Federal Drug Act, a claim for information can be brought to obtain evidence from the defendant or a third party for medicinal products, particularly regarding adverse event data. We are currently seeing a lot of disputes in Germany around this claim for information. The requirements and scope are unclear, which makes it difficult to handle. Complying with such a claim also requires a lot of effort.
Vera Jurgens (Netherlands): Dutch civil procedure does allow pre-trial discovery (Article 843a DCCP – 'exhibition claim'), but this is limited. It requires the claimant to specify the documents sought, demonstrate a 'legitimate interest,' and show that the documents are in the control of the defendant.
However, as of 1 January 2025, the Simplification and Modernisation of Law of Evidence Act has entered into force, including the introduction of the pre-procedural right of inspection. This obliges both opposing parties and third parties to provide relevant information, provided that the conditions for inspection are met. Pursuant to Article 194 DCCP, this results in an extensive disclosure obligation, therefore I wonder whether the PLD will actually make a significant difference.
The UK as a common law country probably already has extensive disclosure obligations in place?
Katie Chandler (UK): Yes – the product liability litigation claims process in England and Wales includes the disclosure rules set out in the Civil Procedural Rules and requires parties to disclose documents in their control (which can extend to documents held by an associated company) on which they rely, and which adversely affect their own case or support another party's case. The duty to disclose is a strict obligation enforced by the court and the duty to disclose known adverse documents is a continuing one. Our procedure has extensive rules on disclosure and legal professional privilege including legal advice and litigation privilege which can, when certain conditions are met, prevent disclosure to the other side. Disclosure is also available at the pre-action stage, if the test is met and in relation to specific disclosure.
We also have well-established procedures for protecting the confidentiality of documents and, in particular, source code and/or other technical documentation or trade secrets including implementing confidentiality ring orders (the terms of which are often the subject of extensive dispute between the parties).
Seán Carroll (Ireland): Ireland also already has a standard discovery process in place for civil cases, including product liability claims. But the disclosure obligations under the new PLD may need clarification from the national law and/or the courts in terms of what is meant by 'relevant evidence' and how this is to be limited to what is 'necessary and proportionate'.
Outlook and how to prepare
How can businesses in your jurisdictions prepare and mitigate the risks of the new liability regime?
ECIJA (Spain): We advise our clients to update their legal and product documentation to comply with the new PLD, implement systems for defect management and traceability and ensure they have adequate insurance coverage, as liability has been expanded.
Christopher Bakier (Austria): We are advising businesses in Austria to proactively map all product components, including software, updates, and third-party integrations, and to clearly define internal responsibilities for lifecycle monitoring and safety updates. Given the broader scope of liability, we recommend reviewing contracts, documentation, and risk allocation along the supply chain. In anticipation of disclosure requests under the new procedural rules, maintaining well-structured technical records and traceability might become increasingly important. Companies should also assess their cyber security and update processes.
Vera Jurgens (Netherlands):
Advisory strategies typically include:
- Early risk assessments: Identifying high-risk products, particularly involving software, AI, or connected devices.
- Internal documentation reviews: Ensuring traceability of product design, updates, testing, and risk mitigation.
- Contractual adjustments: Revisiting supply chain contracts to clarify responsibilities, warranties, indemnities, and documentation obligations.
- Training legal and technical teams: Raising awareness internally about new requirements and liability exposures.
- Proactive monitoring: Putting systems in place for monitoring product performance and field complaints under the new standards.
Katie Chandler (UK):
- Risk assessment: conduct a thorough risk assessment to identify potential risks associated with the technology.
- Draw up technical documentation as required.
- Transparency and IFUs: ensure transparency in AI systems by providing clear explanations of how the AI technology works and how decisions are made.
- Quality assurance: robust quality checks/audits including data quality and security measures to ensure AI systems are accurate, reliable and protected from unauthorised access or misuse. Including testing and validation.
- Insurance coverage: consider obtaining insurance coverage for AI-related risks to mitigate potential financial liabilities.
- Consider how to comply with potential disclosure requests and what this information would look like as well as document repository systems and document retention policies.
- Review supplier contracts and consider updating terms such as exclusions, warranties and provision of documents/disclosure processes.
Lena Niehoff (Germany): I fully agree with my colleagues.
Evelyne Friedel (France): It is recommended to anticipate the forthcoming PLD by updating relevant documentation where necessary, structuring internal processes for incident management and product traceability, taking into account the broadened definition of 'liable party', and adapting insurance coverage to reflect newly identified risks.
Seán Carroll (Ireland): The new PLD reflects a wider EU commitment to strengthening consumer protection. For Irish businesses, it is a clear prompt to begin preparing. Taking action now can help reduce legal and operational risks and offer a strategic advantage as the product liability landscape continues to evolve.
In summary, what are you keeping an eye on regarding the new Product Liability Directive?
Evelyne Friedel (France): A reform of civil liability as a whole has been under consideration in France for several years. The new PLD is seen by some as an opportunity to initiate such a reform.
Lena Niehoff (Germany): It will be interesting to see the new PLD is implemented by Member States by December 2026, and how the national courts apply the new rules.
ECIJA (Spain): Regarding the aforementioned disclosure duties, we consider truly relevant the presumptions in favour of the consumer introduced by Article 10 of the new PLD, which include the application of the 'in re ipsa loquitur' and 'in re ipsa' principles.
Christopher Bakier (Austria): The new PLD will impact software and AI companies, requiring careful handling of technical evidence and trade secrets. How Austrian courts balance disclosure and confidentiality remains to be seen.
Vera Jurgens (Netherlands): We would also like to highlight two additional points:
- Legaltech and compliance tools: Dutch companies should explore tools that help with automated documentation, version control, and audit trails — especially for software-related products. This could be vital evidence under the new regime.
- Interaction with the Digital Services Act and AI Act: There will be an interplay between the new PLD, AI Act, and the Digital Services/Product Liability frameworks. Businesses must prepare holistically, as compliance in one area (eg data transparency under the AI Act) may affect liability under the PLD.
Please contact Lena Niehoff and our International Product Liability and Product Safety team for further information.